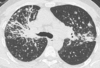
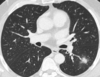
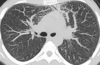
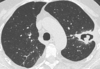
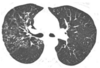
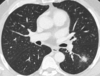

Icono thorax Flashcards
(161 cards)
OAP interstitiel
Lymphangite carcinomateuse
Infarctus pulmonaire
Infarctus pulmonaire :
→ Cadre grillagé » (« central lucencies » en anglo-saxon)
- Condensation périphérique
- Verre dépoli et réticulations intra- lobulaires centrales
Nodule excavé dans un contexte de granulomatose de Wegener
Histiocytose X
Association
- Nodules irréguliers centrolobulaires
- Nodules troués
- Kystes
Prédominance régions supérieures
Cavité tuberculeuse active
Avec diffusion bronchogène (arbres en bourgeon associés)
Lymphangite carcinomateuse
Varicelle
Miliaire tuberculeuse
LAM
→ kystes à contours réguliers
Histiocytose X
→ kystes à contours irréguliers
Lymphangioleiomyomatose

Histiocytose
→ noter le respect des
cul de sac costo-diaphragmatiques

Histiocytose X

Granulome éosinophile costal dans un contexte d’histriocytose X

Lymphangio-léiomyomatose (LAM)
→ kystes de répartition diffuse

Maladie des dépôts d’immunoglobuline
non amyloïde
- Multiples kystes
- Bronchectasies monoliformes

Maladie de Birt Hogg Dubé

Trachéobronchopathie ostéochondroplastique

Trachéobronchomégalie Mounier Kuhn
→ Trachée sous glottique normale ++

Trachée en fourreau de sabre

Papillomes trachéaux multiples

Bronchiolite constrictive